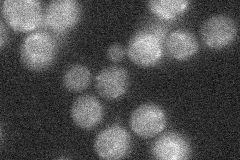
YER180C

View description
Protein required for sporulation, transcript is induced 7.5 hours after induction of meiosis, expected to play significant role in the formation of reproductive cells
Localization:
Intensity:
Fold change:
Significance:
-
C’ GFP library in SD

below threshold17.01 -
N' NOP1pr-GFP in SD

cytosol,punctate83.448 -
N' TEF2pr-mCherry in SD

punctate38.4928 -
N' NATIVEpr-GFP in SD
below threshold19.9213 -
N' TEF2pr-VC and Cyto-VN in SD

punctate30.5142 -
C’ GFP library in SD+DTT

cytosol17.241.01No -
C’ GFP library in SD+H2O2

cytosol16.860.99No -
C’ GFP library in Starvation Media

cytosol15.370.9No -
C’ GFP library on the background of Pup2-DaMP

below threshold -
C’ GFP library on the background of CCT mutant

below threshold16.71530.982305No
